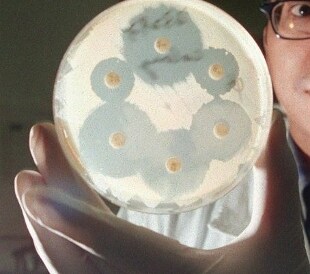

SALUTE
Congresso Internazionale AMIT
In Italia primato di decessi per antibiotico-resistenza
Nel 2050 le infezioni batteriche costituiranno la principale causa di decessi
Il problema delle patologie da batteri multi resistenti è sempre più attuale e tutte le istituzioni internazionali (WHO, OCSE, CDC, ECDC) hanno sviluppato algoritmi e linee guida di gestione. I numeri sono sconvolgenti. I report delle più importanti agenzie sanitarieinternazionali (Organizzazione Mondiale della Sanità, Centro europeo per il Controllo delle Malattie Infettive, Agenzia Europea per la Sicurezza Alimentare, ecc.) riportano come queste resistenze determinano aumenti molto importanti nei decessi dovuti ad infezioni batteriche.
"Attualmente qualunque tipo di infezione, dalle più banali come semplici infezioni cutanee o urinarie, a infezioni gravi, quali polmoniti e sepsi, può essere causato da batteri antibiotico-resistenti. Sembra un paradosso, ma anche una persona che non ha mai preso antibiotici corre il rischio di avere un'infezione da batteri resistenti, soprattutto se si trova in ospedale o nelle altre strutture di assistenza sanitaria. I batteri non conoscono frontiere e le stesse resistenze che si trovano in Europa o negli Stati Uniti si possono evidenziare in villaggi sperduti in Africa ed in America Latina come anche il report dell'OMS dimostra chiaramente" afferma Marco Tinelli, presidente del Congresso AMIT insieme a Massimo Galli, rispettivamente componente del Consiglio Nazionale e presidente della SIMIT - Società Italiana di Malattie Infettive e Tropicali.

